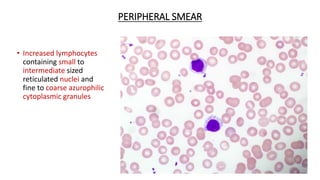
PERIPHERAL SMEAR
• Increased lymphocytes
containing small to
intermediate sized
reticulated nuclei and
fine to coarse azurophilic
cytoplasmic granules

This document provides an overview of T-cell lymphomas, detailing their classification, clinical features, and pathophysiology. It highlights various types, including precursor T-cell neoplasms and mature T-cell neoplasms, along with diagnostic criteria and immunophenotyping characteristics. The document emphasizes the aggressive nature of these malignancies and their association with viral infections, particularly in specific populations.

![IMMUNOHISTOCHEMISTRY
• Diagnosis of exclusion
• Mature T cell phenotype ( CD45RO+, TCRβ+, CD2+, CD3+, CD4+
[frequent], CD5+, CD7+) is most commonly observed
• Loss of CD2 or CD5 favors mycosis fungoides
• Partial loss of CD7 is common.
• TCR gamma, CD8 & EBER are negative.](https://image.slidesharecdn.com/tcelllymphomas-230203143134-39451bd9/85/T-cell-lymphomas-By-Dr-MULUKALA-SWETHA-86-320.jpg)








